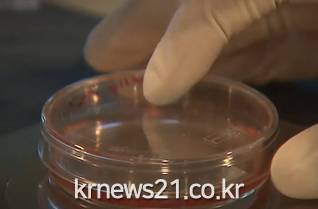

▲ 사진=KBS NEWS 영상 캡처
▲ 사진=KBS NEWS 영상 캡처파킨슨병은 운동을 조절하는 '도파민'을 분비하는 뇌세포가 죽으면서 생기는 질환이다.
연구진은 배아줄기세포를 도파민을 분비하는 신경전구세포로 분화시킨 뒤 환자의 뇌에 주입했다.
이식 후 환자의 뇌 영상 검사를 통해 도파민을 분비하는 뇌 부위가 훨씬 커진걸 확인했다.
뇌에 들어간 도파민 신경전구세포가 도파민을 분비하는 신경세포로 성장했음을 보여준다.
또한, 줄기세포 이식을 받은 환자 3명의 운동 기능이 평균 44% 향상된 것으로 나타났다.
파킨슨병 환자에게 배아줄기세포 이식 치료의 효과를 확인한 건 아시아에서 이번이 처음이다.
 시각장애 교원 특수학급 운영 역량 높인다
[뉴스21일간=이준수 기자] 울산광역시교육청(교육감 천창수)은 31일 중구 가온고등학교 특수학급에서 시각장애 특수교육 교원을 대상으로 ‘특수학급 운영 역량 강화 연수’를 진행했다. 이번 연수는 시각장애 교원이 교육 현장에서 겪는 어려움을 덜고, 안정적으로 특수학급을 운영할 수 있도록 지원하고자 마련됐다.&nb...
시각장애 교원 특수학급 운영 역량 높인다
[뉴스21일간=이준수 기자] 울산광역시교육청(교육감 천창수)은 31일 중구 가온고등학교 특수학급에서 시각장애 특수교육 교원을 대상으로 ‘특수학급 운영 역량 강화 연수’를 진행했다. 이번 연수는 시각장애 교원이 교육 현장에서 겪는 어려움을 덜고, 안정적으로 특수학급을 운영할 수 있도록 지원하고자 마련됐다.&nb...
 울산 학교운영위원장, 건강한 교육공동체 조성에 힘 모은다
[뉴스21일간=이준수 기자] 울산광역시교육청(교육감 천창수)은 31일 외솔회의실에서 울산지역 학교운영위원장을 대상으로 ‘모두의 성장을 위한 바람직한 학교운영위원회의 역할’을 주제로 원탁토론회를 열었다. 이번 토론회는 학교공동체의 건강한 소통과 협력으로 더 나은 민주적 학교 문화를 조성하고자 마련...
울산 학교운영위원장, 건강한 교육공동체 조성에 힘 모은다
[뉴스21일간=이준수 기자] 울산광역시교육청(교육감 천창수)은 31일 외솔회의실에서 울산지역 학교운영위원장을 대상으로 ‘모두의 성장을 위한 바람직한 학교운영위원회의 역할’을 주제로 원탁토론회를 열었다. 이번 토론회는 학교공동체의 건강한 소통과 협력으로 더 나은 민주적 학교 문화를 조성하고자 마련...
 추억 속의 섬마을 시골 학교
[뉴스21일간=김태인 ]
추억 속의 섬마을 시골 학교
[뉴스21일간=김태인 ]
 남해 양때 목장
남해 양때 목장
 제주 대록산
제주특별자치도 서귀포시 표선면 가시리에 위치한 측화산이다(고도:466m). 형태는 전반적으로 가파르고 둥근 산체에 다소 동서로 퍼져 있고, 화구는 정상 쪽에서 숲으로 덮혀 있어 북으로 터진 말굽형 화구로 보이나, 정상부의 동서 봉우리 사이에 둥그렇게 패여 있는 원형 화구를 갖고 있는 화산체이다.조선 시대에 주변에 '녹산장(鹿山...
제주 대록산
제주특별자치도 서귀포시 표선면 가시리에 위치한 측화산이다(고도:466m). 형태는 전반적으로 가파르고 둥근 산체에 다소 동서로 퍼져 있고, 화구는 정상 쪽에서 숲으로 덮혀 있어 북으로 터진 말굽형 화구로 보이나, 정상부의 동서 봉우리 사이에 둥그렇게 패여 있는 원형 화구를 갖고 있는 화산체이다.조선 시대에 주변에 '녹산장(鹿山...

